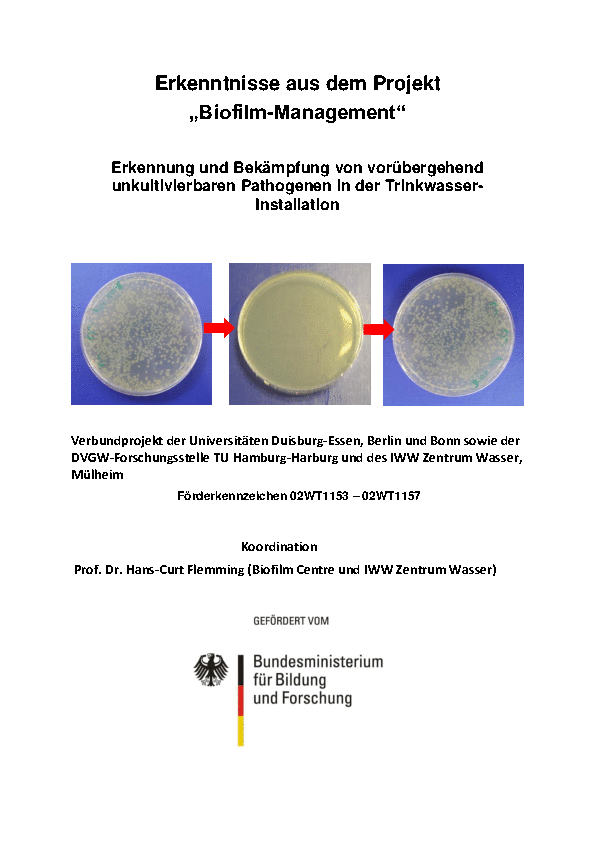

Thesenpapier zum Verbundprojekt „Biofilm-Management“ verfügbar
Essen. Zahlreiche bedeutende Erkenntnisse für die Praxis hat das BMBF-Projekt „Biofilm-Management" geliefert1). Mehr als 20 Partner aus Wissenschaft und Wirtschaft haben im Zeitraum von 2010 bis 2014 daran mitgewirkt. Unter www.biofilm-management.de kann nun ein umfangreiches Thesenpapier kostenlos heruntergeladen werden.
Das 41-seitige wissenschaftliche Werk informiert unter anderem über
- neue Erkenntnisse zur Optimierung der Legionellenüberwachung,
- die Sanierung von kontaminierten Trinkwasser-Installationen,
- erweiterte Nachweismethoden, mit denen unter anderem die Gesamtzellzahl und auch Bakterien im Dämmerzustand nachgewiesen werden können, die mit kulturellen Methoden zeitweise nicht nachweisbar sind, aber unter günstigen Bedingungen wieder aktiv werden und dann zu Kontaminationen führen können (VBNC = Viable but non culturable).
Die Erkenntnisse aus dem Verbundprojekt weisen eine hohe Praxisrelevanz auf. Es ist deshalb nicht ausgeschlossen, dass das Regelwerk zukünftig etwa Nachweismethoden zur Detektion von Bakterien im VBNC-Zustand in Trinkwasser-Installationen enthält. Auch hat das Projekt gezeigt, dass vor einer Desinfektionsmaßnahme eine Installation immer gründlich zu reinigen und die Kontaminationsursache zu beseitigen ist. Mitunter reicht dann ein erhöhter Wasserwechsel aus, um das Sanierungsziel auch ohne Desinfektionsmaßnahme zu erreichen. Ebenfalls eine wichtige Erkenntnis: Bei der routinemäßigen Überwachung von Trinkwasser-Installationen auf Legionellen sind zukünftig die Probenahmestellen in Gebäuden nach erweiterten Gesichtspunkten auszuwählen. Dabei kommen der Nutzung und der Einhaltung der bekannten Wasser-Temperaturen (kalt/warm) in der Peripherie von Gebäuden eine besondere Bedeutung zu.
1) Wir berichteten im Beitrag "Aufschlussreiches Forschungsprojekt - Erkenntnisse aus dem vom Bundesministerium für Bildung und Forschung geförderten Projekt Biofilm-Management und deren Auswirkungen auf die Praxis", IKZ-FACHPLANER, Juli 2014.